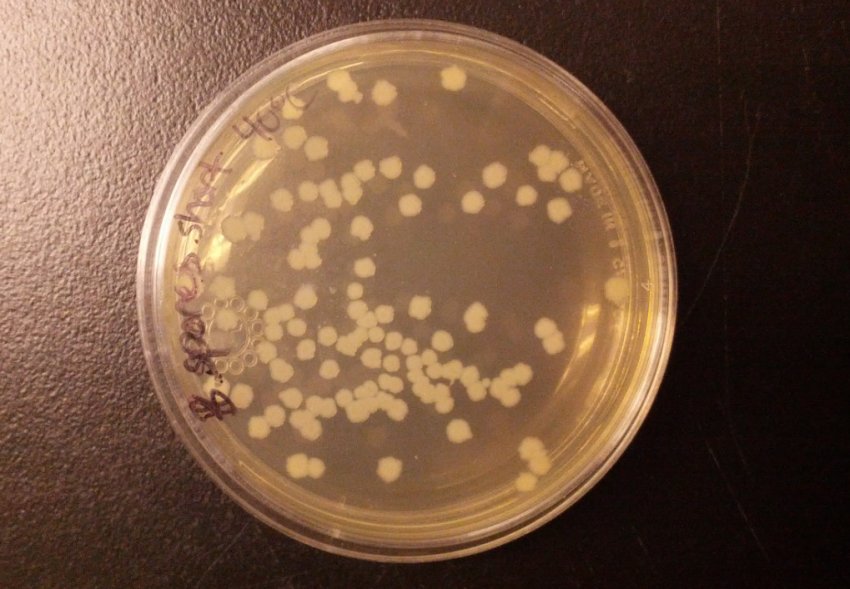
Сінна паличка

Часта проблема при вирощуванні яблунь — чорні плями. Що робити в такому випадку — перше питання, яким повинен задатися садівник, адже це симптом парші яблунь, поширеного захворювання, з яким необхідно боротися. Про те, чим обробити яблуню і як вилікувати цю хворобу, читайте далі у статті.
Чому парша проявляється на яблунях?
Збудник парші — гриб-аскомицет Вентурия нерівна (Venturia inaequalis). Інфекція поширюється через вологу. Небезпека виникає, коли грибок разом з краплями води потрапляє на листя і плоди.
За якими ознаками можна визначити поява парші?
Через 14-21 добу після розпускання бруньок на листках з'являються плями оливкового кольору. Далі покриваються плямами пагони і плоди. Поступово плями стають чорними. Дерево при цьому не припиняє свій ріст. Листя починає опадати з гілок, яблука стають зморшкуватими. Якщо не вилікувати рослину на цьому етапі, грибок залишиться в опалому листі і корі. Наступної весни, коли знову розпустяться бруньки, спори знову дозріють, і почнеться новий цикл зараження.

Способи боротьби з паршею на яблунях
Лікування хвороби можливо за допомогою різних методів — їх можна розділити на народні, хімічні та біологічні засоби. В залежності від ступеня захворювання і можливостей кожен садівник сам вибирає, чим лікувати насадження.
Народними засобами
На перших етапах розвитку захворювання багато дачники вдаються до народних способів лікування. З паршею результативно справляються наступні засоби:
- Розчин марганцівки. Обприскати уражені частини розчином перманганату калію — він повинен бути яскравого фіолетового кольору.
- Розчин польового хвоща. Залийте сировину водою в пропорціях 1:3, закрийте кришкою і відставте на 3 дні. Після закінчення зазначеного строку процідіть розчин. Обприскайте їм крону і стовбур дерева.
- Соляний розчин. Залийте 100 г солі на 1 л води, розмішайте до повного розчинення солі. Обробіть засобом уражені частини рослини.
- Гірчичний розчин. Розчиніть в 1 л води 8-9 г порошку гірчиці. Готовим розчином необхідно обприскати яблуню. Допускається чотири обробки в період вегетації.
- Підживлення. Комплексне мінеральне добриво, внесене при перших симптомах парші, допомагає впоратися з хворобою. Рослина необхідно обприскати розчинами 15% калійної солі, 10% аміачної селітри, 15% калійної селітри і 10% сульфату амонію.

Хімічними засобами
Ефективно з паршею борються фунгіциди. Це загальна назва коштів від грибка, які знищують шкідливі суперечки. Серед найбільш поширених засобів агрономи виділяють наступні:
- «Скор». Препарат готують з розрахунку 2 мл концентрату на відро води. Для лікування необхідно три обприскування. Мінімальний допустимий інтервал між обробками — 20 діб.
- «Стробі». 1 м2 насаджень обприскують 100-150 мл препарату. Всього необхідно три обробки. Час дії активної речовини — 35 діб.
- «Абига-Пік». Для обробки розведіть 5 г засобу в 1 л води. Рекомендовано проводити до чотирьох обприскувань за сезон вегетації. Термін дії препарату — 20 діб.
- «Райок». 1,5–2 мл препарату розводять у відрі води. Зазначеним розчином обприскують насадження чотири рази в період вегетації. Час дії фунгіциду — 20 діб.
Біологічними препаратами
Для боротьби з хворобами плодових дерев агрономи радять використовувати біологічні препарати. Вони менш токсичні, ніж хімічні засоби, проте ефективніше народних методів.
Обробка та профілактичні заходи
Головний спосіб уникнути парші — проводити своєчасну профілактику. Вона відрізняється в залежності від сезону.
Навесні
Перед початком вегетації необхідно провести санітарну обрізку. Садівникові слід видалити всі перемерзлі і зламані гілки. Таким чином, крона буде менш густий, що перешкодить появи хвороби.

- до розпускання бруньок;
- відразу після цвітіння;
- через 14 днів після закінчення цвітіння.

Восени
Після того, як урожай зібраний, слід приступити до осінніх профілактичних робіт. В їх перелік входять наступні заходи:
- прибрати засохлі на гілках і опале плоди;
- обрізати сухі гілки зі стовбура;
- змести обсипалися листя в одну купу і спалити;
- обробити рослину розчином мідного купоросу в концентрації 5%.
Поради досвідчених садівників
Парша шкідлива не тільки для яблунь, але і для інших плодових культур. Не варто нехтувати лікуванням, оскільки весь урожай в саду може бути вражений. Препарати, якими обприскують насадження, краще чергувати. Якщо використовувати засіб з однією діючою речовиною, спори грибка адаптуються і не будуть реагувати на обробки. Дачників часто цікавить, можна обрізати наліт і їсти такі яблука без побоювання. Часто так і роблять, однак грибкові спори можуть перебувати у здорової частини плоду. Такий продукт небезпечний для здоров'я: яблука, уражені захворюванням, варто викидати.
Відео: як боротися з паршею яблуні

Парша яблуні — захворювання дуже поширене, тому обов'язково потрібно задуматися про профілактику. Однак якщо проблема все-таки з'явилася, дерево цілком можна вилікувати. Головне в лікуванні — вибрати правильний метод і своєчасно почати обробки.








